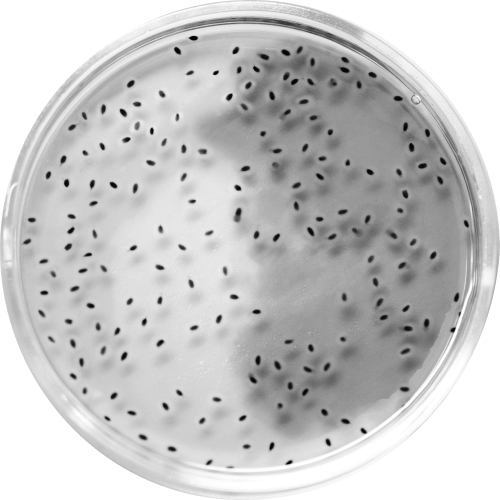

Science for kids: How to conduct experiments and talk to scientists /

6 weeks
/

90 minutes
/

1 lesson a week
/

live lessons online

ABOUT THE COURSE
By the end of this course, you’ll be able to conduct basic Science experiments and describe them in English. You will meet with experts from different fields of science and ask them questions that interest you.
Conducting basic experiments:
- putting objects in water
- magnetic fields and how to see them
- proprioception and body illusions
Describing experiments:
- osmosis experiment – building a hypothesis
- the ice tray experiment – working with data
Meeting scientists:
- prepare questions
- meet the scientist and hold a discussion




requirements
your English is on A2 level or higer
9-11
Course participants will use an oven or a microwave and a freezer.
A2+
you are 9-11 years old

BASIC
A1
Can understand and use familiar everyday expressions and very basic phrases aimed at the satisfaction of needs of a concrete type. Can introduce him/herself and others and can ask and answer questions about personal details such as where he/she lives, people he/she knows and things he/she has. Can interact in a simple way provided the other person talks slowly and clearly and is prepared to help.
A2
Can understand sentences and frequently used expressions related to areas of most immediate relevance (e.g. very basic personal and family information, shopping, local geography, employment). Can communicate in simple and routine tasks requiring a simple and direct exchange of information on familiar and routine matters. Can describe in simple terms aspects of his/her background, immediate environment and matters in areas of immediate need.

INDEPENDENT
B1
Can understand the main points of clear standard input on familiar matters regularly encountered in work, school, leisure, etc. Can deal with most situations likely to arise whilst travelling in an area where the language is spoken. Can produce simple connected text on topics which are familiar or of personal interest. Can describe experiences and events, dreams, hopes & ambitions and briefly give reasons and explanations for opinions and plans.
B2
Can understand the main ideas of complex text on both concrete and abstract topics, including technical discussions in his/her field of specialisation. Can interact with a degree of fluency and spontaneity that makes regular interaction with native speakers quite possible without strain for either party. Can produce clear, detailed text on a wide range of subjects and explain a viewpoint on a topical issue giving the advantages and disadvantages of various options.

PROFICIENT
C1
Can understand a wide range of demanding, longer texts, and recognise implicit meaning. Can express him/herself fluently and spontaneously without much obvious searching for expressions. Can use language flexibly and effectively for social, academic and professional purposes. Can produce clear, well-structured, detailed text on complex subjects, showing controlled use of organisational patterns, connectors and cohesive devices.
C2
Can understand with ease virtually everything heard or read. Can summarise information from different spoken and written sources, reconstructing arguments and accounts in a coherent presentation. Can express him/herself spontaneously, very fluently and precisely, differentiating finer shades of meaning even in more complex situations.
COUNCIL OF EUROPE PORTAL – Common European Framework of Reference for Languages (CEFR)
Who will enjoy the course
Practicians
Learners of English who learn best by doing.
Fun seekers
Those who need good company to conduct simple and fun experiments and discuss them.
Science lovers
Curious kids who are interested in Science and want to find out more about it.






Why you should learn Science
and why Science really matters
1 800 000
academic articles are published each year in English
>8 800 000
1-2 weeks
the total amount of scientists in the world
an average lenght of a scientific experiment



It’s hard to say how many scientists speak English, but for most major conferences and scientific journals, English is the working language.


Conduct basic experiments – learn the vocabulary to describe them
Learn more about object properties, magnets, and human perception patterns
Describe experiments – learn how to develop and validate hypotheses, collect and process data and draw conclusions
Meet scientists – read their bio, prepare questions, meet the scientist and hold a discussion (and a follow-up discussion if needed)
We will meet once a week to conduct the experiment and discuss it.
Meetings with scientists will be online and they won’t be recorded. At the meeting you'll learn about the area of science our guests work in, find out more about their daily routine, challenges and discoveries, ask them questions and take quizzes from the scientists
Meetings with scientists will be online and they won’t be recorded. At the meeting you'll learn about the area of science our guests work in, find out more about their daily routine, challenges and discoveries, ask them questions and take quizzes from the scientists
Learning process
flexibility












1
2
3
4
course outline


lesson 1.
Introductory meeting. Object properties
How do different objects and substances behave in water? Will they float, sink or dissolve? Why?
Course expectations, participants’ experience and interests
1
2
lesson 2.


Magnets
How do we observe something invisible? Where can we see magnetic fields?
Conducting a simple magnet experiment
1
2

lesson 3.
Proprioception. Signals from our body.

How does our brain process the information it receives from our body?
How do we trick our brain? Proprioception experiments and brain illusions
1
2

lesson 4.
Meeting scientist I
You will understand how authors make their vocabulary choices.
You will consider the variety of perspectives from which texts are written.
1
2
You will analyze the impact of style and tone on meaning making.
3


lesson 5.
Science basics. How to build an experiment
The osmosis experiment – building a hypothesis
The ice tray experiment – how to work with data
1
2

lesson 6.
Meeting scientist II
You will compare how the main idea is rendered in non-fiction and poetry.
1

teacher
I grew up in a family of biologists, engineers and veterinary doctors and I had tons of questions on how the world around me works. I am still curious, and being able to read articles and studies in English is incredibly helpful.
The course will be your first step to reading scientific materials and describing your experiment results in English. We will familiarize ourselves with the community of professional scientists, and this is the point many curious experimenters will find the most exciting.
Learning science is an endless road, and I’ll be thrilled to take the first step with you!
The course will be your first step to reading scientific materials and describing your experiment results in English. We will familiarize ourselves with the community of professional scientists, and this is the point many curious experimenters will find the most exciting.
Learning science is an endless road, and I’ll be thrilled to take the first step with you!

English Teacher, Psychologist, keen Experimenter
Alyona Shvets

Pricing
Atom
Molecule
Cell
Group chat with your mates and access to additional resources
The course starts as soon as the group forms*
Personalized feedback for each home assignment
Full access to the lessons and home tasks for a single person
2.
1.
4.
3.
2.
Group chat with your mates and access to additional resources
The course starts as soon as the group forms*
Personalized feedback for each home assignment
Full access to the lessons and home tasks for TWO people
1.
3.
2.
Group chat with your mates and access to additional resources
The course starts right away
Full access to the lessons and home tasks for a whole group (4+ students)
1.
4.
3.




149
249
99
*
The groups are considered formed starting from 4 people.
You pay for the whole group as it is a group offer.
The prices are the following:
Read more about the payment process
- group of 4-5 people: €119/person
- group of 6-7 people: €109/person
- group of 8 people: €99/person
The tariffs “Atom” and “Molecule” may require some additional time for the rest of the group to be formed.
The tariff “Cell” is cheaper, but CAN’T be purchased for a single person.
€/person
€/pair
€/person*
from
Atom
Molecule
Cell
Group chat with your mates and access to additional resources
The course starts as soon as the group forms*
Personalized feedback for each home assignment
Full access to the lessons and home tasks for a single person
2.
1.
4.
3.
2.
Group chat with your mates and access to additional resources
The course starts as soon as the group forms*
Personalized feedback for each home assignment
Full access to the lessons and home tasks for TWO people
1.
3.
2.
Group chat with your mates and access to additional resources
The course starts right away
Full access to the lessons and home tasks for a whole group (4+ students)
1.
4.
3.




145
240
95
*
The groups are considered formed starting from 4 people.
You pay for the whole group as it is a group offer.
The prices are the following:
Read more about the payment process
- group of 4-5 people: $115/person
- group of 6-7 people: $105/person
- group of 8 people: $95/person
The tariffs “Atom” and “Molecule” may require some additional time for the rest of the group to be formed.
The tariff “Cell” is cheaper, but CAN’T be purchased for a single person.
$/person
$/pair
$/person*
from
Atom
Molecule
Cell
Group chat with your mates and access to additional resources
The course starts as soon as the group forms*
Personalized feedback for each home assignment
Full access to the lessons and home tasks for a single person
2.
1.
4.
3.
2.
Group chat with your mates and access to additional resources
The course starts as soon as the group forms*
Personalized feedback for each home assignment
Full access to the lessons and home tasks for TWO people
1.
3.
2.
Group chat with your mates and access to additional resources
The course starts right away
Full access to the lessons and home tasks for a whole group (4+ students)
1.
4.
3.




9 699
16 199
6 499
*
The groups are considered formed starting from 4 people.
You pay for the whole group as it is a group offer.
The prices are the following:
Read more about the payment process
- group of 4-5 people: 7 799 ₽/person
- group of 6-7 people: 7 099 ₽/person
- group of 8 people: 6 499 ₽/person
The tariffs “Atom” and “Molecule” may require some additional time for the rest of the group to be formed.
The tariff “Cell” is cheaper, but CAN’T be purchased for a single person.
₽/person
₽/pair
₽/person*
from
You have chosen the pricing option ATOM for the course SCIENCE FOR KIDS
Leave your full name and email address below. We will contact you for the details and payment within 48 hours.
You have chosen the pricing option MOLECULE for the course SCIENCE FOR KIDS
Leave your full name and email address below. We will contact you for the details and payment within 48 hours.
You have chosen the pricing option CELL for the course SCIENCE FOR KIDS
Leave your full name and email address below. We will contact you for the details and payment within 48 hours.
Still have questions?
Not sure about the pricing options? Something remains unclear?
By clicking the “Send” button you agree to our privacy policy.
Fill the form and we will reach you!



PRIVACY POLICY
This Privacy Policy governs the manner in which Language for Geeks collects, uses, maintains and discloses information collected from users (each, a "User") of the languageforgeeks.com website ("Site"). This privacy policy applies to the Site and all products and services offered by Language for Geeks.
Personal identification information
We may collect personal identification information from Users (in a variety of ways, including, but not limited to,) when Users fill out a form, subscribe to the newsletter, and in connection with other activities, services, features or resources we make available on our Site. Users may be asked for, as appropriate, name, email address, phone number. Users may, however, visit our Site anonymously. We will collect personal identification information from Users only if they voluntarily submit such information to us. Users can always refuse to supply personally identification information, except that it may prevent them from engaging in certain Site related activities.
How we use collected information
Language for Geeks will use the information you provide on the form to be in touch with you and to provide updates about our current or upcoming courses by email.
Email address may also be used to respond to User’s inquiries, questions, and/or other requests. The User may be added to our mailing list and receive emails that may include company news, updates, related product or service information, etc. If at any time the User would like to unsubscribe from receiving future emails, they may do so by contacting us via our Site.
Sharing your personal information
We do not sell, trade, or rent Users personal identification information to others.
Changes to this privacy policy
Language for Geeks has the discretion to update this privacy policy at any time. When we do, we will revise the updated date at the bottom of this page. We encourage Users to frequently check this page for any changes to stay informed about how we are helping to protect the personal information we collect. You acknowledge and agree that it is your responsibility to review this privacy policy periodically and become aware of modifications.
Contacting us
If you have any questions about this Privacy Policy, the practices of this site, or your dealings with this site, please contact us at:
Language for Geeks
languageforgeeks@gmail.com
This document was last updated on March 30, 2022
Personal identification information
We may collect personal identification information from Users (in a variety of ways, including, but not limited to,) when Users fill out a form, subscribe to the newsletter, and in connection with other activities, services, features or resources we make available on our Site. Users may be asked for, as appropriate, name, email address, phone number. Users may, however, visit our Site anonymously. We will collect personal identification information from Users only if they voluntarily submit such information to us. Users can always refuse to supply personally identification information, except that it may prevent them from engaging in certain Site related activities.
How we use collected information
Language for Geeks will use the information you provide on the form to be in touch with you and to provide updates about our current or upcoming courses by email.
Email address may also be used to respond to User’s inquiries, questions, and/or other requests. The User may be added to our mailing list and receive emails that may include company news, updates, related product or service information, etc. If at any time the User would like to unsubscribe from receiving future emails, they may do so by contacting us via our Site.
Sharing your personal information
We do not sell, trade, or rent Users personal identification information to others.
Changes to this privacy policy
Language for Geeks has the discretion to update this privacy policy at any time. When we do, we will revise the updated date at the bottom of this page. We encourage Users to frequently check this page for any changes to stay informed about how we are helping to protect the personal information we collect. You acknowledge and agree that it is your responsibility to review this privacy policy periodically and become aware of modifications.
Contacting us
If you have any questions about this Privacy Policy, the practices of this site, or your dealings with this site, please contact us at:
Language for Geeks
languageforgeeks@gmail.com
This document was last updated on March 30, 2022









